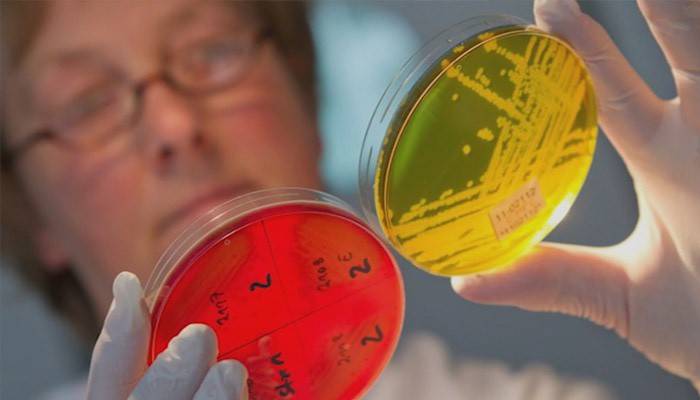

Drogas com bifidobactérias para os intestinos
A palavra "bifidobactéria" foi ouvida por muitos - muitas vezes soa em comerciais de televisão. Apenas poucas pessoas pensam sobre o que é. O fato de que eles são úteis e necessários é conhecido por médicos e pacientes que foram submetidos a tratamento com antibióticos. Familiarizado com eles são mães lactentes com misturas artificiais. As bifidobactérias para os intestinos desempenham um papel muito importante. Eles participam dos processos digestivos, e sua deficiência leva a disbiose com sérias conseqüências. Vamos tentar descobrir o que são as bifidobactérias.
O que é bifidobactéria?

No intestino grosso existem microrganismos que se desenvolvem sem ar. Eles não são capazes de causar doenças, sua tarefa é alimentar, proteger, limpar. Esses microorganismos são chamados de bifidobactérias. Eles aparecem desde o momento do nascimento e acompanham uma pessoa durante toda a sua vida. Com a ajuda deles, ocorre:
- normalização da digestão;
- síntese de vitaminas;
- absorção mineral;
- a absorção de aminoácidos;
- redistribuição de nutrientes;
- peristaltismo adequado;
- aumentar a imunidade;
- controle de alergia;
- melhoria do sistema linfático.
Microflora intestinal
Cerca de quinhentas espécies de bactérias vivem nos intestinos humanos - entre elas, microrganismos benéficos e nocivos. Se tudo estiver em ordem com a saúde, eles estão em equilíbrio. Útil ajuda a normalizar a digestão dos alimentos, participar na absorção de nutrientes, a formação de vitaminas. Eles compõem a maioria nos intestinos. Bactérias prejudiciais estão envolvidas nos processos de decomposição, fermentação. Em caso de um mau funcionamento do corpo, ocorre um desequilíbrio da microflora - disbiose.
Bifidobactérias para o trabalho do intestino e manter o equilíbrio da microflora são muito importantes. Juntamente com lactobacilos, enterococos, bacteroides, eles:
- normalizar o metabolismo;
- suprimir bactérias putrefactive;
- contribuir para a absorção de nutrientes;
- formar imunoglobulina A;
- participar do processo de digestão;
- regular o colesterol;
- contribuir para a decomposição de proteínas.
Deficiência de bifidobactérias

Quando o número de bifidobactérias diminui por várias razões, ocorre um desequilíbrio. Bactérias putrefativas estão ativamente crescendo, envenenando o corpo. Ele começa a envelhecer rapidamente. Além disso, ocorrem sintomas desagradáveis que pioram a qualidade de vida, levam ao aparecimento de doenças graves. Se a situação não for corrigida a tempo - se o tratamento não for iniciado - a disbiose pode levar a tristes conseqüências.
Sintomas
Quando ocorre uma deficiência de bifidobactérias para o intestino - devido ao peristaltismo prejudicado - a estagnação começa, levando à constipação. Existem complicações na forma de infecções intestinais. Além disso, a disbiose é acompanhada por:
- diarréia
- arrotos devido a processos de fermentação;
- dor e peso no abdômen;
- mau hálito;
- flatulência;
- fadiga.
Razões possíveis
Se falamos sobre as causas da disbiose, então, em primeiro lugar, será o uso de drogas. Estes são antibióticos, medicamentos anti-inflamatórios não esteróides, hormônios. Além disso, entre as possíveis razões, observe:
- dieta insalubre;
- doenças crônicas do trato gastrointestinal;
- mudança hormonal em mulheres durante a gravidez;
- imunidade diminuída;
- infecções intestinais;
- situações estressantes;
- inatividade física;
- alimentação artificial de bebês;
- Beber álcool.
As conseqüências
O aparecimento de uma deficiência de bifidobactérias no intestino tem sérias consequências. Bactérias nocivas começam a deslocar as benéficas. A comida não é digerida, sua podridão, a fermentação começa. Uma intoxicação do corpo ocorre. Além de interromper o processo de digestão, surgem outros problemas:
- a imunidade é reduzida;
- infecções intestinais se desenvolvem;
- alergias aparecem;
- gastrite é provocada;
- as doenças virais estão se tornando mais freqüentes;
- aumento de fadiga;
- fraqueza aparece;
- concentração de atenção diminui;
- surgem problemas psicológicos.
Recuperação da microflora intestinal
Grande esforço é necessário para restaurar a microflora intestinal. Você deveria mudar sua vida:
- organizar nutrição adequada e equilibrada;
- introduzir produtos lácteos fermentados na dieta;
- Não coma demais;
- beba bastante água de boa qualidade;
- mover ativamente;
- tomar medicamentos especiais;
- use remédios populares.
Nutrição adequada
Um importante papel na restauração da microflora intestinal é dado à nutrição adequada. Deve ser fracionário - 6 vezes ao dia. Não beba comida com água. É necessário reduzir carboidratos rápidos na dieta - doces, pão branco, batatas. Limite o consumo de carne. Um ambiente favorável nos intestinos é criado por:
- vegetais e frutas ricos em fibras;
- produtos de ácido láctico;
- pão integral;
- cebola, alho;
- fibra grossa - trigo mourisco, arroz integral;
- farelo;
- suco de chucrute;
- maçãs encharcadas;
- pão kvass.
Medicamentos para a restauração da microflora intestinal

Para restaurar a microflora no intestino, além de probióticos contendo bactérias vivas, é necessário tomar prebióticos, que criam um ambiente favorável ao seu desenvolvimento. Quantos e quais medicamentos tomar são decididos pelo médico. Ele se familiariza com o histórico médico, estuda as instruções para medicamentos. O tratamento intestinal é realizado usando drogas para disbiose. De acordo com o número de bactérias contidas:
- Monocomponente. Eles contêm um tipo de bactéria - Biovestin, Bifidumbacterin.
- Simbióticos Eles têm vários tipos de bactérias - Biovestin-Lacto, Linex, Acipol.
O uso de simbióticos é muito eficaz - drogas que contêm simultaneamente probióticos, prebióticos. Estes incluem Bifidumbacterin 1000, Algibif. Separadamente, deve ser dito sobre o tratamento da disbiose em bebês. Para o bebê, o melhor remédio é o leite materno. O principal é que ela não tem disbiose. Recomenda-se que as crianças mais velhas comam misturas contendo probióticos vivos e prebióticos:
- Agusha Gold;
- "NAS premium";
- Semilak Premium
- "Prebio sem precedentes."
Probióticos
Drogas e produtos úteis para a restauração da microflora - probióticos contêm microrganismos vivos. Entre eles estão bifidobactérias, lactobacilos. Probióticos para os intestinos são encontrados em produtos de ácido láctico, onde a tecnologia de cozimento permite que você salve bactérias vivas. Existem medicamentos especiais que os contêm em sua composição:
- "Acipol";
- "Bifidumbacterina";
- Linex
Os probióticos agem de maneira diferente no corpo:
- Os lactobacilos ajudam a digerir produtos lácteos. Destrua micróbios patogênicos, aumente a imunidade. Localizado no intestino, estômago, saliva.
- Bifidobactérias para o intestino contribuem para o descarte de alimentos não digeridos. Eles limpam o corpo dos produtos do trato gastrointestinal. Eles são encontrados apenas no intestino grosso.
Prebióticos

Substâncias naturais que criam um ambiente especial para o crescimento e desenvolvimento de bactérias benéficas no intestino são chamadas de prebióticos. Sua presença no intestino humano contribui para:
- aumentar a imunidade;
- ativar o crescimento da microflora;
- redução no número de bactérias patogênicas;
- melhorar a motilidade intestinal;
- restauração de microflora intestinal.
Prebióticos estão disponíveis sob a forma de comprimidos, cápsulas, supositórios. Existem drogas na forma de xaropes líquidos. Prebióticos são populares: Dufalac, Lactofiltrum, Maxilac. Desde que é necessário usá-los em conjunto com probióticos para restaurar a microflora, há preparações complexas que contêm ambas as substâncias, por exemplo, Bifidumbacterin 1000. Prebióticos contêm alimentos naturais:
- Alcachofra de Jerusalém;
- alho, cebola;
- bananas
- farelo;
- farinha de trigo.
Remédios populares para disbiose
É possível tratar disbiose em adultos com a ajuda de um remédio muito barato - alho. É necessário de manhã, antes do café da manhã e 2 horas após o jantar, comer um dente de alho. Você pode cozinhar iogurte de alho. É bebido para o tratamento e prevenção de disbiose. Para cozinhar, você deve:
- ponha pão marrom durante um dia em leite;
- adicione algumas bolachas de centeio raladas com alho ao produto fermentado;
- Fique 2 horas - iogurte está pronto.
Remédio barato e muito eficaz para disbiose em crianças pequenas. Você precisará de um kefir fresco. Quantidade - 10 gramas por quilograma de peso da criança. Kefir é aquecido à temperatura do corpo e colocar um enema no bebê. Um produto lácteo fermentado destrói bactérias patogênicas. As crianças estão felizes em beber chá medicinal para disbiose. Um litro de água deve adicionar uma colher grande de flores de camomila e ferver. Beba em qualquer quantidade, acrescentando mel a gosto.
Medidas preventivas
Para que seus intestinos funcionem corretamente, bactérias prejudiciais e benéficas estão em equilíbrio, um número de condições deve ser observado:
- evitar situações estressantes;
- fortalecer o sistema nervoso;
- mover ativamente;
- tomar junto com antibióticos para as preparações especiais do intestino para restaurar a microflora;
- organizar a nutrição adequada;
- lavar legumes e frutas;
- não abuse de antibióticos;
- microflora de restauração oportuna;
- Beba muita água.

